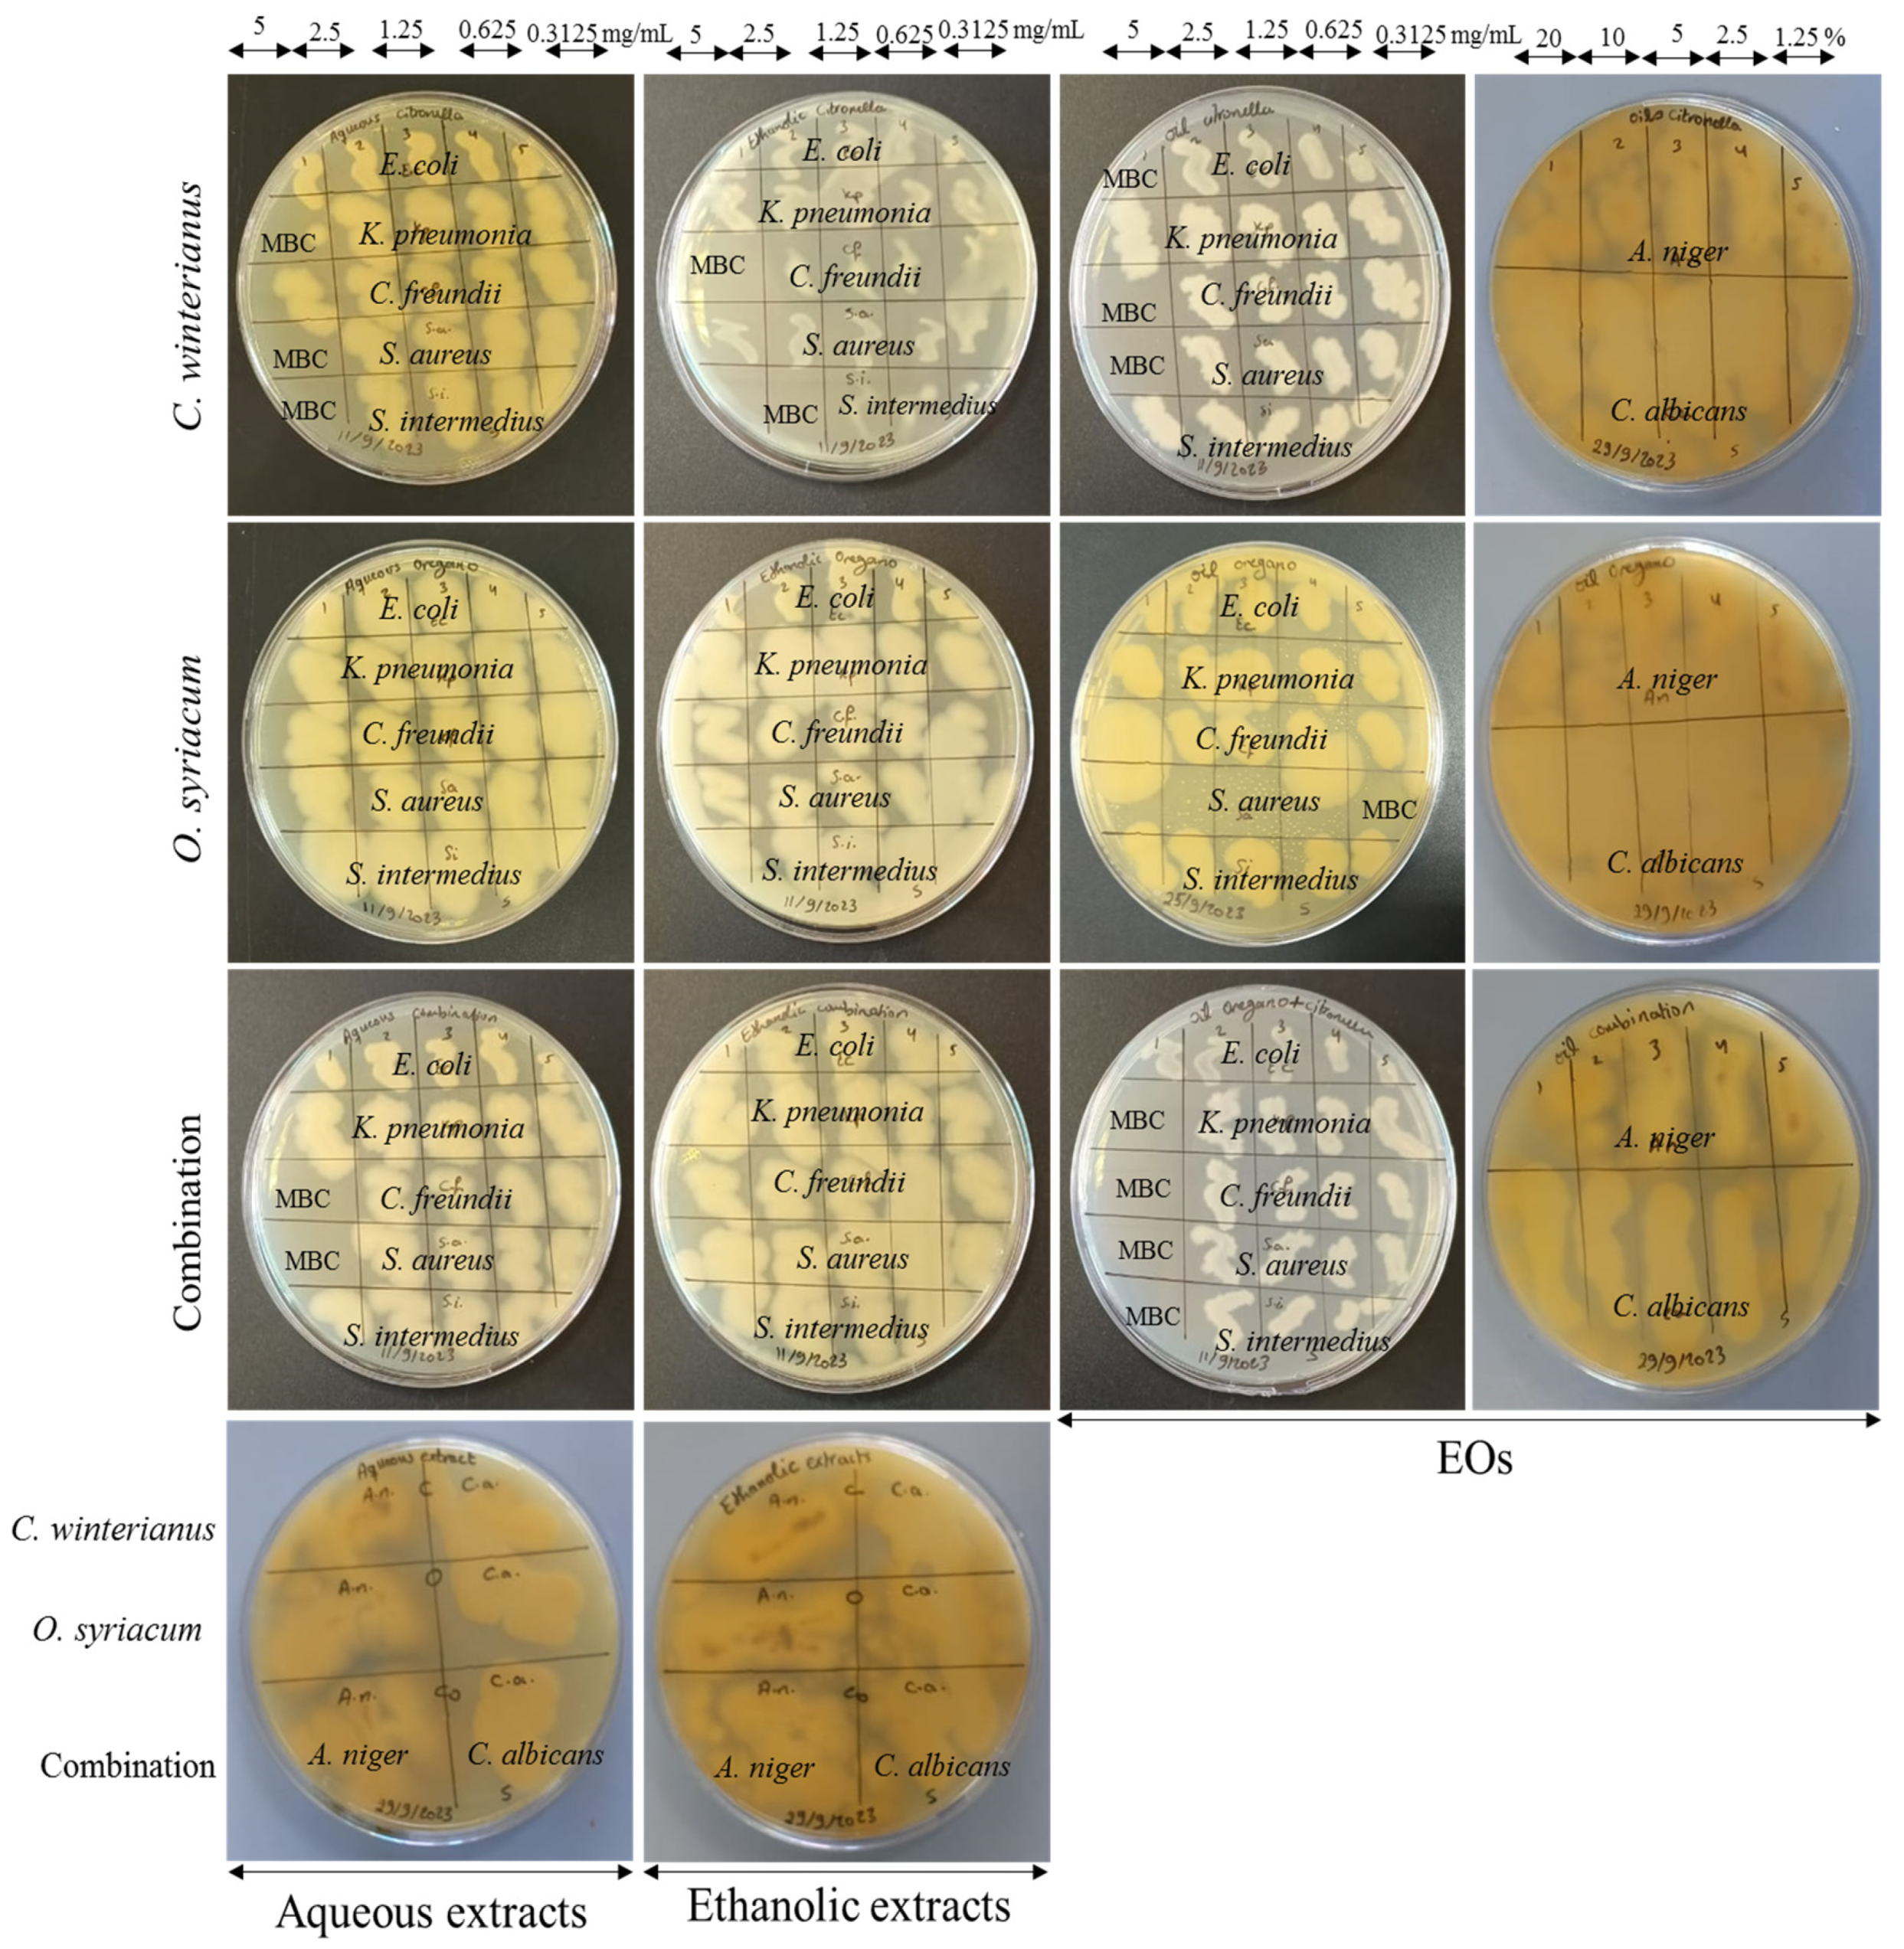
Foods 13 01684 g001

Antibacterial and Antifungal Activities of Cimbopogon winterianus and Origanum syriacum Extracts and Essential Oils against Uropathogenic Bacteria and Foodborne Fungal Isolates
Abstract
1. Introduction
2. Materials and Methods
2.1. Isolation and Identification of the Bacterial and Fungal Isolates
2.2. Preparation of the Aqueous and Ethanolic O. syriacum and C. winterianus Extracts and EOs
2.3. Minimum Inhibitory Concentration (MIC) and Minimum Bactericidal/Fungicidal (MBC/MFC) of the Aqueous and Ethanolic O. syriacum and C. winterianus Extracts and EOs by the Microdilution Assay
2.4. Determination of the Time Needed by the Aqueous and Ethanolic O. syriacum and C. winterianus Extracts and EOs to Inhibit Bacterial and Fungal Growth by the Time-Kill Assay
2.5. Detection of the Anti-Biofilm Activity of the Aqueous and Ethanolic O. syriacum and C. winterianus Extracts and EOs by the Anti-Biofilm Assay
2.6. Preparation of the Film
2.7. Statistical Analysis
3. Results
3.1. Minimum Inhibitory Concentration (MIC) and Minimum Bactericidal Concentration/Minimum Fungicidal Concentration (MBC/MFC) of the Aqueous and Ethanolic O. syriacum and C. winterianus Extracts and EOs
3.2. Time-Kill Results of the Aqueous and Ethanolic O. syriacum and C. winterianus Extracts and EOs against the Bacterial and Fungal Isolates
3.3. Antibiofilm Activity of the Aqueous and Ethanolic O. syriacum and C. winterianus Extracts and EOs against the Bacterial and Fungal Isolates
3.4. Destruction of Pre-Formed Biofilms
3.5. Preservation of the Table Grapes by the Prepared Film
4. Discussion

5. Conclusions
Supplementary Materials
Author Contributions
Funding
Institutional Review Board Statement
Informed Consent Statement
Data Availability Statement
Conflicts of Interest
References
- Gontard, N.; Guillard, V.; Gaucel, S.; Guillaume, C. L’emballage alimentaire et l’innovation écologique dans toutes leurs dimensions. Innov. Agron. 2017, 58, 1–9. [Google Scholar]
- Odjo, K.; Al-Maqtari, Q.A.; Yu, H.; Xie, Y.; Guo, Y.; Li, M.; Du, Y.; Liu, K.; Chen, Y.; Yao, W. Preparation and characterization of chitosan-based antimicrobial films containing encapsulated lemon essential oil by ionic gelation and cranberry juice. Food Chem. 2022, 397, 133781. [Google Scholar] [CrossRef] [PubMed]
- Perera, K.Y.; Jaiswal, A.K.; Jaiswal, S. Biopolymer-Based Sustainable Food Packaging Materials: Challenges, Solutions, and Applications. Foods 2023, 12, 2422. [Google Scholar] [CrossRef] [PubMed]
- Avramescu, S.M.; Butean, C.; Popa, C.V.; Ortan, A.; Moraru, I.; Temocico, G. Edible and functionalized films/coatings-performances and perspectives. Coatings 2020, 10, 687. [Google Scholar] [CrossRef]
- Chaudhary, P.; Fatima, F.; Kumar, A. Relevance of Nanomaterials in Food Packaging and Its Advanced Future Prospects. J. Inorg. Organomet. Polym. Mater. 2020, 30, 5180–5192. [Google Scholar] [CrossRef] [PubMed]
- Hou, X.; Xue, Z.; Xia, Y.; Qin, Y.; Zhang, G.; Liu, H.; Li, K. Effect of SiO2 nanoparticle on the physical and chemical properties of eco-friendly agar/sodium alginate nanocomposite film. Int. J. Biol. Macromol. 2019, 125, 1289–1298. [Google Scholar] [CrossRef] [PubMed]
- Mostafavi, F.S.; Zaeim, D. Agar-based edible films for food packaging applications—A review. Int. J. Biol. Macromol. 2020, 159, 1165–1176. [Google Scholar] [CrossRef] [PubMed]
- Breceda-Hernandez, T.G.; Martínez-Ruiz, N.R.; Serna-Guerra, L.; Hernández-Carrillo, J.G. Effect of a pectin edible coating obtained from orange peels with lemon essential oil on the shelf life of table grapes (Vitis vinifera L. var. Red. Globe). Int. Food Res. J. 2020, 27, 585–596. [Google Scholar]
- Arnon, H.; Granit, R.; Porat, R.; Poverenov, E. Development of polysaccharides-based edible coatings for citrus fruits: A layer-by-layer approach. Food Chem. 2015, 166, 465–472. [Google Scholar] [CrossRef]
- Nottagh, S.; Hesari, J.; Peighambardoust, S.H.; Rezaei-Mokarram, R.; Jafarizadeh-Malmiri, H. Effectiveness of edible coating based on chitosan and Natamycin on biological, physico-chemical and organoleptic attributes of Iranian ultra-filtrated cheese. Biologia 2020, 75, 605–611. [Google Scholar] [CrossRef]
- Karaca, H.; Pérez-Gago, M.B.; Taberner, V.; Palou, L. Evaluating food additives as antifungal agents against Monilinia fructicola in vitro and in hydroxypropyl methylcellulose-lipid composite edible coatings for plums. Int. J. Food Microbiol. 2014, 179, 72–79. [Google Scholar] [CrossRef] [PubMed]
- do Nascimento, A.; Toneto, L.C.; Lepaus, B.M.; Valiati, B.S.; Faria-Silva, L.; de São José, J.F.B. Effect of Edible Coatings of Cassava Starch Incorporated with Clove and Cinnamon Essential Oils on the Shelf Life of Papaya. Membranes 2023, 13, 772. [Google Scholar] [CrossRef] [PubMed]
- Yaradoddi, J.; Banapurmath, N.; Ganachari, D.S.; Soudagar, M.E.; Sajjan, A.; Kamat, S.; Abbas, M.M.; Shettar, A.; Anqi, A.; Safaei, M.R.; et al. Bio-based Material from Fruit Waste of Orange Peel for Industrial Applications. J. Mater. Res. Technol. 2021, 17, 3186–3197. [Google Scholar] [CrossRef]
- Mohamad, R.; Mussa, R.; Suslina, S.N. Prospects for using Origanum syriacum (L.) as a source of antimicrobial agents. J. Adv. Pharm. Technol. Res. 2021, 12, 340–344. [Google Scholar] [CrossRef]
- Mesmar, J.; Abdallah, R.; Badran, A.; Maresca, M.; Baydoun, E. Origanum syriacum Phytochemistry and Pharmacological Properties: A Comprehensive Review. Molecules 2022, 27, 4272. [Google Scholar] [CrossRef] [PubMed]
- Daouk, R.K.; Dagher, S.M.; Sattout, E.J. Antifungal Activity of the Essential Oil of Origanum syriacum L. J. Food Prot. 1995, 58, 1147–1149. [Google Scholar] [CrossRef] [PubMed]
- Dangol, S.; Poudel, D.K.; Ojha, P.K.; Maharjan, S.; Poudel, A. Essential Oil Composition Analysis of Cymbopogon Species from Eastern Nepal by GC-MS and Chiral GC-MS, and Antimicrobial Activity of Some Major Compounds. Molecules 2023, 28, 543. [Google Scholar] [CrossRef] [PubMed]
- Liu, D.; Zhao, P.; Chen, J.; Yan, Y.; Wu, Z. Recent Advances and Applications in Starch for Intelligent Active Food Packaging: A Review. Foods 2022, 11, 2879. [Google Scholar] [CrossRef]
- Mezher, M.; El Hajj, R.; Khalil, M. Investigating the antimicrobial activity of essential oils against pathogens isolated from sewage sludge of southern Lebanese villages. Germs 2022, 12, 488–506. [Google Scholar] [CrossRef]
- Rammal, M.; Badran, A.; Haidar, C.; Sabbah, A.; Bechelany, M.; Awada, M.; Hassan, K.H.; El-Dakdouki, M.; Raad, M.T. Cymbopogon winterianus (Java Citronella Plant): A Multi-Faceted Approach for Food Preservation, Insecticidal Effects, and Bread Application. Foods 2024, 13, 803. [Google Scholar] [CrossRef]
- Adnan, R.M.; Mezher, M.; Abdallah, A.M.; Awad, R.; Khalil, M.I. Synthesis, Characterization, and Antibacterial Activity of Mg-Doped CuO Nanoparticles. Molecules 2023, 28, 103. [Google Scholar] [CrossRef] [PubMed]
- Adnan, R.; Abdallah, A.M.; Mezher, M.; Noun, M.; Khalil, M.; Awad, R. Impact of Mg-doping on the structural, optical, and magnetic properties of CuO nanoparticles and their antibiofilm activity. Phys. Scr. 2023, 98, 55935. [Google Scholar] [CrossRef]
- Tarique, J.; Sapuan, S.M.; Khalina, A. Effect of glycerol plasticizer loading on the physical, mechanical, thermal, and barrier properties of arrowroot (Maranta arundinacea) starch biopolymers. Sci. Rep. 2021, 11, 13900. [Google Scholar] [CrossRef] [PubMed]
- Preuss, H.G.; Echard, B.; Enig, M.; Brook, I.; Elliott, T.B. Minimum inhibitory concentrations of herbal essential oils and monolaurin for gram-positive and gram-negative bacteria. Mol. Cell. Biochem. 2005, 272, 29–34. [Google Scholar] [CrossRef] [PubMed]
- Al-Mariri, A.; Safi, M. In Vitro Antibacterial Activity of Several Plant Extracts and Oils against Some Gram-Negative Bacteria. Iran. J. Med. Sci. 2014, 39, 36. [Google Scholar]
- AL-Mariri, A.; Odeh, A.; Alobeid, B.; Boukai, H. In Vitro Antibacterial Activity of Origanum syriacum L. Essential Oils against Gram-Negative Bacteria. Avicenna J. Clin. Microbiol. Infect. 2019, 6, 26–30. [Google Scholar] [CrossRef]
- Singh, G.; Katoch, M. Antimicrobial activities and mechanism of action of Cymbopogon khasianus (Munro ex Hackel) Bor essential oil. BMC Complement. Med. Ther. 2020, 20, 331. [Google Scholar] [CrossRef] [PubMed]
- Mangalagiri, N.P.; Panditi, S.K.; Jeevigunta, N.L.L. Antimicrobial activity of essential plant oils and their major components. Heliyon 2021, 7, e06835. [Google Scholar] [CrossRef]
- Simic, A.; Rančic, A.; Sokovic, M.D.; Ristic, M.; Grujic-Jovanovic, S.; Vukojevic, J.; Marin, P.D. Essential Oil Composition of Cymbopogon winterianus and Carum carvi and Their Antimicrobial Activities. Pharm. Biol. 2008, 46, 437–441. [Google Scholar] [CrossRef]
- Swamy, M.K.; Akhtar, M.S.; Sinniah, U.R. Antimicrobial properties of plant essential oils against human pathogens and their mode of action: An updated review. Evidence-based Complement. Altern. Med. 2016, 2016, 3012462. [Google Scholar] [CrossRef]
- Bhavaniramya, S.; Vishnupriya, S.; Al-Aboody, M.S.; Vijayakumar, R.; Baskaran, D. Role of essential oils in food safety: Antimicrobial and antioxidant applications. Grain Oil Sci. Technol. 2019, 2, 49–55. [Google Scholar] [CrossRef]
- Nazzaro, F.; Fratianni, F.; De Martino, L.; Coppola, R.; De Feo, V. Effect of essential oils on pathogenic bacteria. Pharmaceuticals 2013, 6, 1451–1474. [Google Scholar] [CrossRef] [PubMed]
- Anastasiou, T.I.; Mandalakis, M.; Krigas, N.; Vézignol, T.; Lazari, D.; Katharios, P.; Dailianis, T.; Antonopoulou, E. Comparative Evaluation of Essential Oils from Medicinal-Aromatic Plants of Greece: Chemical Composition, Antioxidant Capacity and Antimicrobial Activity against Bacterial Fish Pathogens. Molecules 2019, 25, 148. [Google Scholar] [CrossRef] [PubMed]
- Coccimiglio, J.; Alipour, M.; Jiang, Z.-H.; Gottardo, C.; Suntres, Z. Antioxidant, Antibacterial, and Cytotoxic Activities of the Ethanolic Origanum vulgare Extract and Its Major Constituents. Oxidative Med. Cell. Longev. 2016, 2016, 1404505. [Google Scholar] [CrossRef] [PubMed]
- Iseppi, R.; Tardugno, R.; Brighenti, V.; Benvenuti, S.; Sabia, C.; Pellati, F.; Messi, P. Phytochemical composition and in vitro antimicrobial activity of essential oils from the lamiaceae family against streptococcus agalactiae and candida albicans biofilms. Antibiotics 2020, 9, 592. [Google Scholar] [CrossRef] [PubMed]
- Famuyide, I.M.; Aro, A.O.; Fasina, F.O.; Eloff, J.N.; McGaw, L.J. Antibacterial and antibiofilm activity of acetone leaf extracts of nine under-investigated south African Eugenia and Syzygium (Myrtaceae) species and their selectivity indices. BMC Complement. Altern. Med. 2019, 19, 141. [Google Scholar] [CrossRef]
- Aires, A.; Barreto, A.S.; Semedo-Lemsaddek, T. Antimicrobial effects of essential oils on oral microbiota biofilms: The toothbrush in vitro model. Antibiotics 2021, 10, 21. [Google Scholar] [CrossRef]
- Liang, J.; Huang, X.; Ma, G. Antimicrobial activities and mechanisms of extract and components of herbs in East Asia. RSC Adv. 2022, 12, 29197–29213. [Google Scholar] [CrossRef]

| Plant Extracts and EOs | MICs and MBCs/MFCs of the Extracts (mg/mL) and the Oils (%) | Bacterial Isolates | Fungal Isolates | |||||
|---|---|---|---|---|---|---|---|---|
| Gram-Negative Bacteria | Gram-Positive Bacteria | |||||||
| E. coli | K. pneumonia | C. freundii | S. aureus | S. intermedius | C. albicans | A. niger | ||
| C. winterianus AE | MIC | 5 | 2.5 | 2.5 | 2.5 | 2.5 | - | 5 |
| MBC/MFC | - | 5 | - | 5 | 5 | - | - | |
| O. syriacum AE | MIC | 2.5 | 2.5 | 1.25 | 1.25 | 1.25 | - | 5 |
| MBC/MFC | - | - | - | - | - | - | - | |
| Combination of AE | MIC | 2.5 | 2.5 | 1.25 | 2.5 | 2.5 | - | 5 |
| MBC/MFC | - | - | 5 | 5 | - | - | - | |
| C. winterianus EE | MIC | 2.5 | 1.25 | 2.5 | 0.625 | 1.25 | 5 | 5 |
| MBC/MFC | - | - | 5 | - | 2.5 | - | - | |
| O. syriacum EE | MIC | - | 2.5 | 1.25 | 1.25 | 2.5 | 5 | 5 |
| MBC/MFC | - | - | - | - | - | - | - | |
| Combination of EE | MIC | 2.5 | 1.25 | 2.5 | 5 | 5 | 2.5 | 5 |
| MBC/MFC | - | - | - | - | - | - | - | |
| C. winterianus EO | MIC | 2.5 | 2.5 | 5 | 2.5 | 2.5 | 1.25 | 1.25 |
| MBC/MFC | 20 | - | 20 | 20 | - | - | 10 | |
| O. syriacum EO | MIC | 2.5 | 1.25 | 1.25 | - | 1.25 | 2.5 | 5 |
| MBC/MFC | - | - | 20 | 1.25 | - | - | 10 | |
| Combination of EOs | MIC | 20 | 5 | 5 | 5 | 5 | 5 | 5 |
| MBC/MFC | - | 20 | 20 | 20 | 20 | - | 10 | |
| Plant | Extracts and EOs | MICs of Extracts and EOs | Reference | ||||
|---|---|---|---|---|---|---|---|
| Bacterial Isolates | Fungal Isolates | ||||||
| E. coli | K. pneumonia | S. aureus | A. niger | C. albicans | |||
| Origanum | EO | 0.5 mg/mL | 0.5 mg/mL | 0.5 mg/mL | - | - | [24] |
| Monolaurin | EO | >8 mg/mL | >8 mg/mL | 0.063 mg/mL | - | - | |
| O. syriacum | AE | 12.5 µg/mL | 6.25 C | - | - | - | [25] |
| O. syriacum | EO | - | 40 µg/mL | - | - | - | [26] |
| C. khasianus | EO | 20 V | 20 µg/mL | 30 µg/mL | - | 100 µg/mL | [27] |
| C. winterianus | EO | 0.98 µg/mL | - | 0.98 µg/mL | - | - | [28] |
| C. winterianus | EO | 6 µg/mL | - | 2 µg/mL | 2.5 µg/mL | 1 µg/mL | [29] |
| O. syriacum and C. winterianus | Combined AEs | 2.5 mg/mL | 2.5 mg/mL | 2.5 mg/mL | 5 mg/mL | - | Current study |
| Combined EEs | 2.5 mg/mL | 1.25 mg/mL | 5 mg/mL | 5 mg/mL | 2.5 mg/mL | ||
| Combined EOs | 20% | 5% | 5% | 5% | 5% | ||
| Plant Extracts and Oils | Time of Inhibition (h) of Bacterial and Fungal Isolates | ||||||
|---|---|---|---|---|---|---|---|
| Bacterial Isolates | Fungal Isolates | ||||||
| Gram-Negative Bacteria | Gram-Positive Bacteria | ||||||
| E. coli | K. pneumonia | C. freundii | S. aureus | S. intermedius | C. albicans | A. niger | |
| C. winterianus AE | 24 | 2 | 24 | 2 | 2 | 4 | 2 |
| O. syriacum AE | 24 | 1 | 2 | 2 | 2 | 1 | 1 |
| Combination of AEs | 1 | 1 | 1 | 2 | 24 | 2 | 1 |
| C. winterianus EE | 24 | 24 | 24 | 24 | 24 | 1 | 1 |
| O. syriacum EE | 24 | 24 | 24 | 24 | 24 | 2 | 1 |
| Combination of EEs | 24 | 24 | 24 | 24 | 24 | 2 | 2 |
| C. winterianus EO | 2 | 2 | 4 | 1 | 1 | 1 | 1 |
| O. syriacum EO | 1 | 2 | 4 | 24 | 2 | 2 | 2 |
| Combination of EOs | 1 | 4 | 1 | 1 | 2 | 4 | 4 |
Disclaimer/Publisher’s Note: The statements, opinions and data contained in all publications are solely those of the individual author(s) and contributor(s) and not of MDPI and/or the editor(s). MDPI and/or the editor(s) disclaim responsibility for any injury to people or property resulting from any ideas, methods, instructions or products referred to in the content. |
© 2024 by the authors. Licensee MDPI, Basel, Switzerland. This article is an open access article distributed under the terms and conditions of the Creative Commons Attribution (CC BY) license (https://creativecommons.org/licenses/by/4.0/).
Share and Cite
Rammal, M.; Khreiss, S.; Badran, A.; Mezher, M.; Bechelany, M.; Haidar, C.; Khalil, M.I.; Baydoun, E.; El-Dakdouki, M.H. Antibacterial and Antifungal Activities of Cimbopogon winterianus and Origanum syriacum Extracts and Essential Oils against Uropathogenic Bacteria and Foodborne Fungal Isolates. Foods 2024, 13, 1684. https://doi.org/10.3390/foods13111684
Rammal M, Khreiss S, Badran A, Mezher M, Bechelany M, Haidar C, Khalil MI, Baydoun E, El-Dakdouki MH. Antibacterial and Antifungal Activities of Cimbopogon winterianus and Origanum syriacum Extracts and Essential Oils against Uropathogenic Bacteria and Foodborne Fungal Isolates. Foods. 2024; 13(11):1684. https://doi.org/10.3390/foods13111684
Chicago/Turabian StyleRammal, Marwa, Salam Khreiss, Adnan Badran, Malak Mezher, Mikhael Bechelany, Chaden Haidar, Mahmoud I. Khalil, Elias Baydoun, and Mohammad H. El-Dakdouki. 2024. "Antibacterial and Antifungal Activities of Cimbopogon winterianus and Origanum syriacum Extracts and Essential Oils against Uropathogenic Bacteria and Foodborne Fungal Isolates" Foods 13, no. 11: 1684. https://doi.org/10.3390/foods13111684
APA StyleRammal, M., Khreiss, S., Badran, A., Mezher, M., Bechelany, M., Haidar, C., Khalil, M. I., Baydoun, E., & El-Dakdouki, M. H. (2024). Antibacterial and Antifungal Activities of Cimbopogon winterianus and Origanum syriacum Extracts and Essential Oils against Uropathogenic Bacteria and Foodborne Fungal Isolates. Foods, 13(11), 1684. https://doi.org/10.3390/foods13111684

